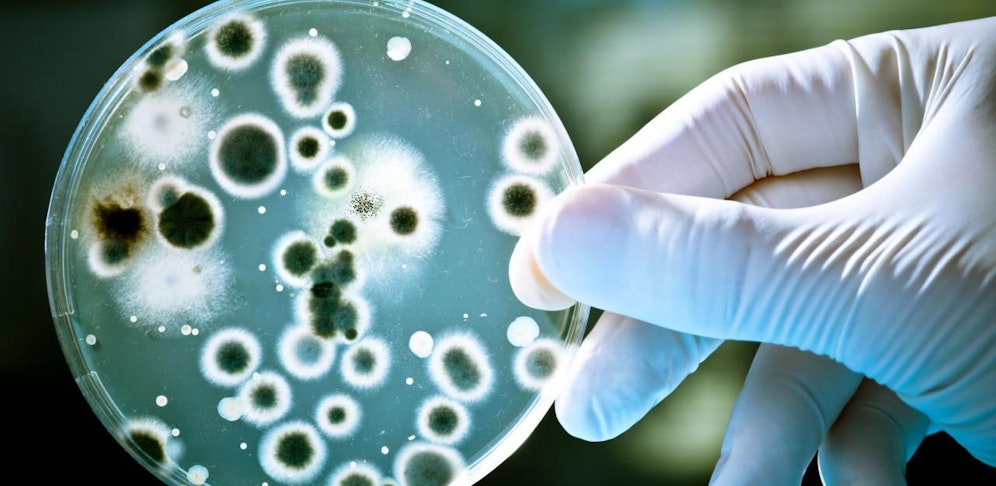

Wo Blähungen entweichen zu lassen zu Auszeichnungen führen kann, ist die Welt noch in Ordnung. Ein Urbakterium, das durch Furzen Biomethan erzeugt, wurde in einem Projekt zu erneuerbaren Energien in der Schweiz ausgezeichnet.
Das Stadtwerk Radio Energie Solothurn in der Schweiz ist der diesjährige Preisträger des "Watt D'Or". Das Bundesamt für Energie zeichnet das Projekt in der Kategorie "erneuerbare Energien" für ein Urbakterium aus, das durch Furzen Biomethan erzeugt. Urbakterien (sogenannte Archaeen) "fressen" Wasserstoff und CO2 und bilden daraus Biomethan. Der Vorgang der biologischen Methanisierung wird im Hybridwerk realisiert. Das Urbakterium darf dort „munter vor sich hinfurzen", wie das Schweizer Bundesamt für Energie (BFE) am Donnerstag mitteilte.
Für den Preis prämiert werden Schweizer Hochschulen, die die "Energiezukunft bereits heute erfolgreich und mutig in die Praxis umsetzen". Die ETH Zürich erhielt eine Auszeichnung in der Kategorie "Gebäude und Raum". Die Forscher setzten eine erneuerbare Wärmeversorgung am Campus Hönggerberg um. Die Versorgung speichert im Sommer Bodenabwärme, die im Winter zum Heizen verwendet wird.